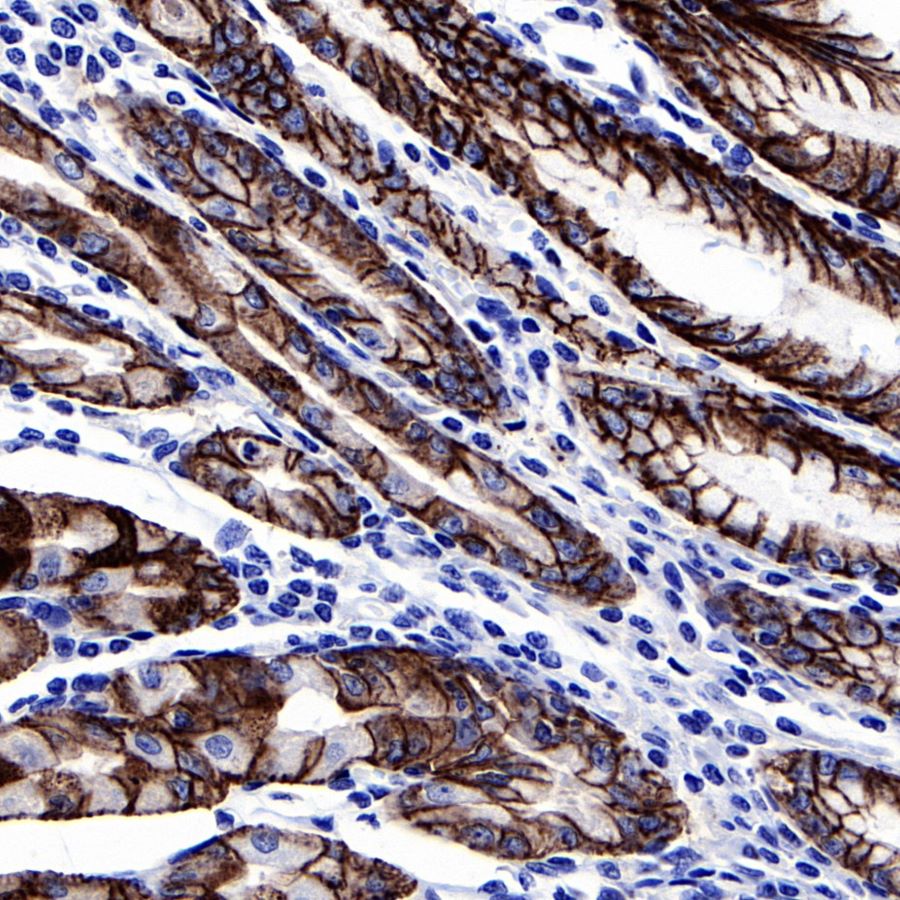

Product Specification
| Host |
Rabbit |
| Antigen |
Claudin18.2 |
| Immunogen |
Synthetic Peptide |
| Location |
Membrane |
| Accession |
P56856-2 |
| Clone Number |
SDT-102-83 |
| Antibody Type |
Rabbit mAb |
| Application |
IHC-P |
| Reactivity |
Hu, Ms, Rt |
| Purification |
Protein A |
| Concentration |
0.5 mg/ml |
| Physical Appearance |
Liquid |
| Storage Buffer |
PBS, 40% Glycerol, 0.05%BSA, 0.03% Proclin 300 |
| Stability & Storage |
12 months from date of receipt / reconstitution, -20 °C as supplied |
Dilution
| application |
dilution |
species |
| IHC-P |
1:1000 |
null |
Background
Claudin-18 is a protein that in humans is encoded by the CLDN18 gene. It belongs to the group of claudins. CLDN18 belongs to the large claudin family of proteins, which form tight junction strands in epithelial cells. Isoform 2 (Claudin 18.2) is abundant in gastric tumors. Claudin 18.2 is involved in tumor development and progression and located in the outer cell membrane. It has exposed extracellular loops and is available for monoclonal antibody binding.